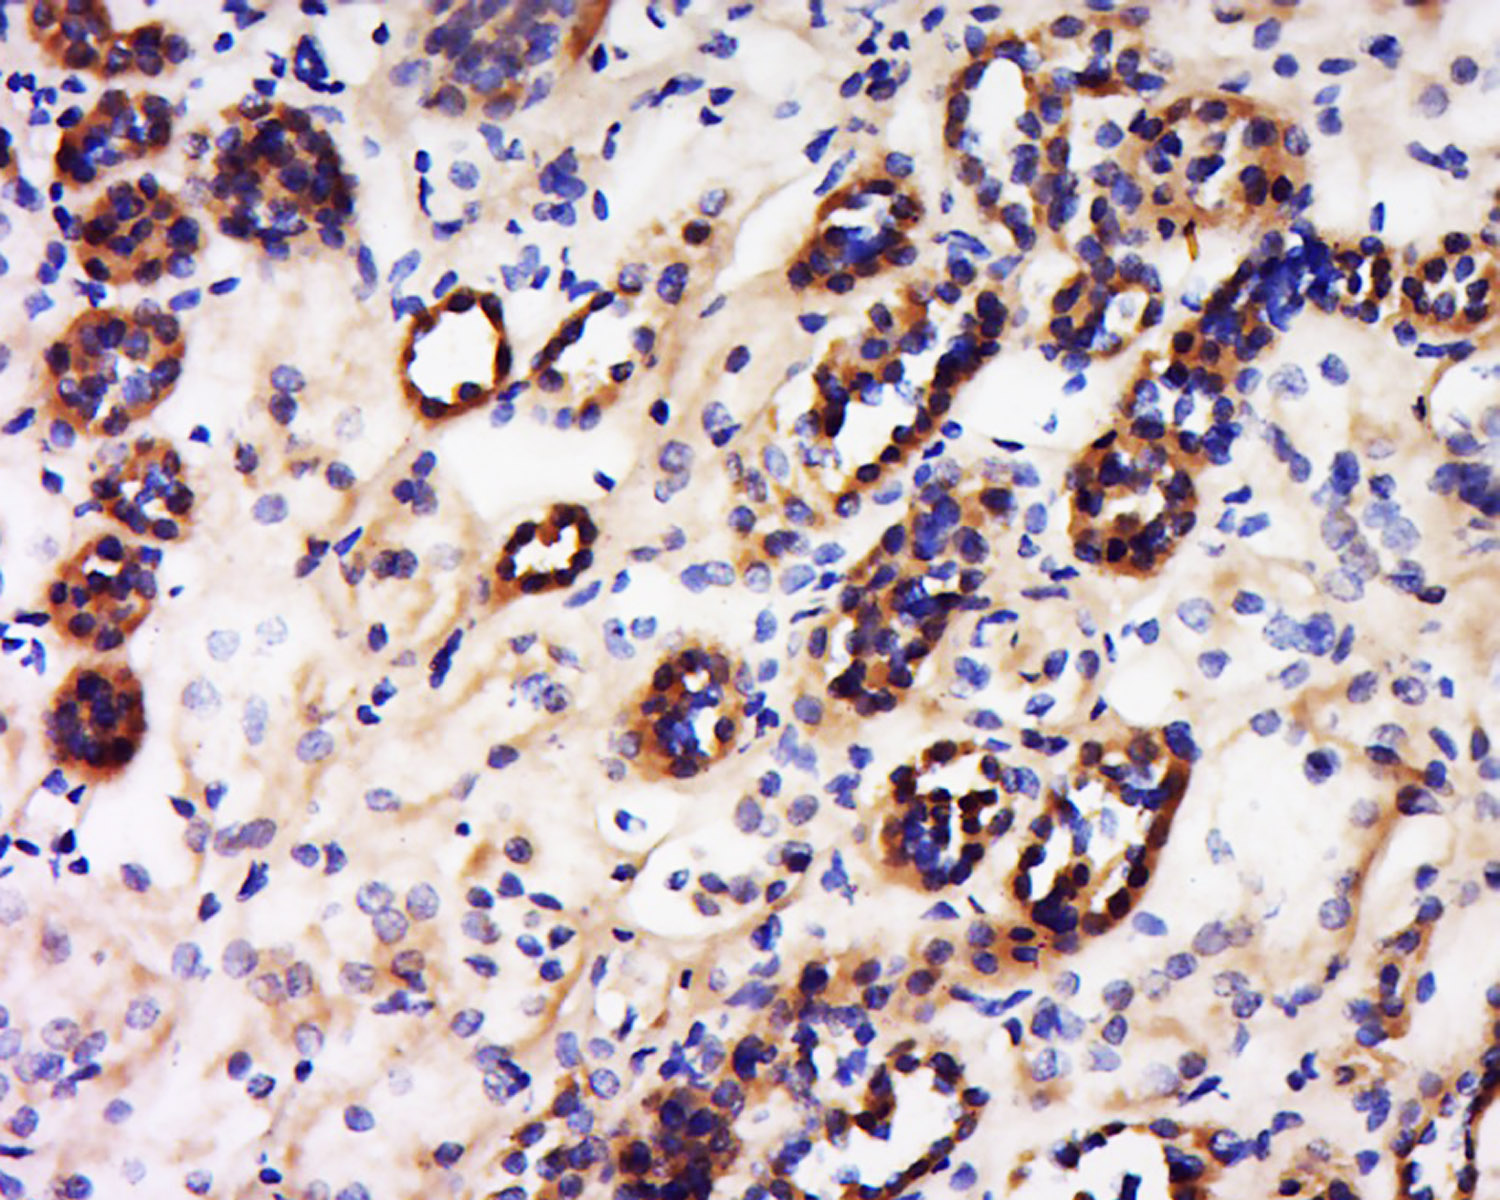
phospho-VEGF receptor 2 (Tyr10

相关产品推荐更多 >

IGF2 Rabbit pAb, PE conjugated(bs-0015R-PE)-100ul
¥2980
EMR2 Rabbit pAb, Biotin conjugated(bs-13634R-Bio)-100ul
¥2980
Integrin Alpha V + Beta 6 Rabbit pAb, PerCP-Cy5.5 conjugated(bs-5791R-PerCP-Cy5.5)-100ul
¥2980
TCP1 alpha Rabbit pAb(bs-12292R)-50ul/100ul/200ul
¥1180
phospho-PDGFRA (Tyr754) Rabbit pAb, BF594 conjugated(bs-20280R-BF594)-100ul
¥2980
万千商家帮你免费找货
0 人在求购买到急需产品
- 详细信息
- 文献和实验
- 技术资料
- 应用范围:
产品信息以Bioss网站为准
- 规格:
50ul/100ul/200ul
| 规格: | 50ul | 产品价格: | ¥1180.0 |
|---|---|---|---|
| 规格: | 100ul | 产品价格: | ¥1980.0 |
| 规格: | 200ul | 产品价格: | ¥2800.0 |
| 产品编号 | bs-3467R |
| 英文名称 | phospho-VEGF receptor 2 (Tyr1059) Rabbit pAb |
| 中文名称 | 磷酸化血管内皮生长因子受体2抗体 |
| 英文别名 | VEGFR2(phospho-Tyr1059); VEGFR2(phospho-Y1059); p-VEGFR2(Tyr1059); p-VEGFR2(Y1059); CD309; CD309 antigen; Fetal liver kinase 1; FLK-1; FLK1; KDR; Kinase insert domain receptor(a type III receptor tyrosine kinase); Kinase insert domain receptor; KRD1; Ly73; Protein tyrosine kinase receptor FLK1; Protein-tyrosine kinase receptor flk-1; Tyrosine kinase growth factor receptor; Vascular endothelial growth factor receptor 2; VEGFR 2; VEGFR; VEGFR-2; VEGFR2; VGFR2_HUMAN. |
| 产品应用 | WB=1:500-2000, IHC-P=1:100-500, IHC-F=1:100-500, IF=1:100-500, Flow-Cyt=2ug/test Not yet tested in other applications. |
| 交叉反应 | Human (Mouse, Rat, Chicken, Dog, Pig, Cow, Horse, Rabbit) |
| 抗体来源 | Rabbit |
| 免疫原 | KLH conjugated Synthesised phosphopeptide derived from human VEGF receptor 2 around the phosphorylation site of Tyr1059 |
| 亚型 | IgG |
| 性状 | Liquid |
| 纯化方法 | affinity purified by Protein A |
| 克隆类型 | Polyclonal |
| 理论分子量 | 147 kDa |
| 浓度 | 1mg/ml |
| 储存液 | 0.01M TBS (pH7.4) with 1% BSA, 0.02% Proclin300 and 50% Glycerol. |
| 研究领域 | Cancer > Cancer Metabolism > Response to hypoxia Cancer > Growth factors > VEGF Cancer > Invasion/microenvironment > Angiogenesis > Angiogenic growth factors Cancer > Oncoproteins/suppressors > Oncoproteins > Growth factor receptors Cardiovascular > Angiogenesis > Endothelial Cell Markers Cardiovascular > Angiogenesis > Growth Factors > VEGF > VEGF Receptors Cardiovascular > Cardiovascular Markers > Cell Markers > Endothelial Cells Metabolism > Pathways and Processes > Metabolism processes > Hypoxia Microbiology > Interspecies Interaction > Host Virus Interaction Signal Transduction > Growth Factors/Hormones > VEGF Signal Transduction > Protein Phosphorylation > Tyrosine Kinases > Receptor Tyrosine Kinases Stem Cells > Endothelial Progenitors > Endothelial Markers Stem Cells > Hematopoietic Progenitors > Surface Molecules |
| 亚基 | Interacts with MYOF. Interacts with VEGFA, VEGFC and VEGFD. Monomer in the absence of bound VEGFA, VEGFC or VEGFD. Homodimer in the presence of bound dimeric VEGFA, VEGFC or VEGFD. Can also form heterodimers with FLT1 and FLT4. Interacts (tyrosine phosphorylated) with FYN, NCK1, PLCG1 and SHB. Interacts with HIV-1 Tat. Interacts with CBL. Interacts with SH2D2A/TSAD and GRB2. |
| 亚细胞定位 | Isoform 1: Cell membrane; Single-pass type I membrane protein. Cytoplasm. Nucleus. Cytoplasmic vesicle. Early endosome. Note=Detected on caveolae-enriched lipid rafts at the cell surface. Is recycled from the plasma membrane to endosomes and back again. Phosphorylation triggered by VEGFA binding promotes internalization and subsequent degradation. VEGFA binding triggers internalization and translocation to the nucleus.
Isoform 2: Secreted (Probable). Isoform 3: Secreted. |
| 组织特异性 | Detected in cornea (at protein level). Widely expressed. |
| 翻译后修饰 | N-glycosylated.
Ubiquitinated. Tyrosine phosphorylation of the receptor promotes its poly-ubiquitination, leading to its degradation via the proteasome or lysosomal proteases. Autophosphorylated on tyrosine residues upon ligand binding. Autophosphorylation occurs in trans, i.e. one subunit of the dimeric receptor phosphorylates tyrosine residues on the other subunit. Phosphorylation at Tyr-951 is important for interaction with SH2D2A/TSAD and VEGFA-mediated reorganization of the actin cytoskeleton. Phosphorylation at Tyr-1175 is important for interaction with PLCG1 and SHB. Phosphorylation at Tyr-1214 is important for interaction with NCK1 and FYN. Dephosphorylated by PTPRB. Dephosphorylated by PTPRJ at Tyr-951, Tyr-996, Tyr-1054, Tyr-1059, Tyr-1175 and Tyr-1214. |
| 相似性 | Belongs to the protein kinase superfamily. Tyr protein kinase family. CSF-1/PDGF receptor subfamily.
Contains 7 Ig-like C2-type (immunoglobulin-like) domains. Contains 1 protein kinase domain. |
| 功能 | Tyrosine-protein kinase that acts as a cell-surface receptor for VEGFA, VEGFC and VEGFD. Plays an essential role in the regulation of angiogenesis, vascular development, vascular permeability, and embryonic hematopoiesis. Promotes proliferation, survival, migration and differentiation of endothelial cells. Promotes reorganization of the actin cytoskeleton. Isoforms lacking a transmembrane domain, such as isoform 2 and isoform 3, may function as decoy receptors for VEGFA, VEGFC and/or VEGFD. Isoform 2 plays an important role as negative regulator of VEGFA-and VEGFC-mediated lymphangiogenesis by limiting the amount of free VEGFA and/or VEGFC and preventing their binding to FLT4. Modulates FLT1 and FLT4 signaling by forming heterodimers. Binding of vascular growth factors to isoform 1 leads to the activation of several signaling cascades. Activation of PLCG1 leads to the production of the cellular signaling molecules diacylglycerol and inositol 1,4,5-trisphosphate and the activation of protein kinase C. Mediates activation of MAPK1/ERK2, MAPK3/ERK1 and the MAP kinase signaling pathway, as well as of the AKT1 signaling pathway. Mediates phosphorylation of PIK3R1, the regulatory subunit of phosphatidylinositol 3-kinase, reorganization of the actin cytoskeleton and activation of PTK2/FAK1. Required for VEGFA-mediated induction of NOS2 and NOS3, leading to the production of the signaling molecule nitric oxide (NO) by endothelial cells. Phosphorylates PLCG1. Promotes phosphorylation of FYN, NCK1, NOS3, PIK3R1, PTK2/FAK1 and SRC. |
| 保存条件 | Shipped at 4℃. Store at -20℃ for one year. Avoid repeated freeze/thaw cycles. |
| 注意事项 | This product as supplied is intended for research use only, not for use in human, therapeutic or diagnostic applications. |
| 背景资料 | Vascular endothelial growth factor (VEGF) is a major growth factor for endothelial cells. This gene encodes one of the two receptors of the VEGF. This receptor, known as kinase insert domain receptor, is a type III receptor tyrosine kinase. It functions as the main mediator of VEGF-induced endothelial proliferation, survival, migration, tubular morphogenesis and sprouting. The signalling and trafficking of this receptor are regulated by multiple factors, including Rab GTPase, P2Y purine nucleotide receptor, integrin alphaVbeta3, T-cell protein tyrosine phosphatase, etc.. Mutations of this gene are implicated in infantile capillary hemangiomas. [provided by RefSeq, May 2009]. |
| 应用 | 推荐稀释比例 |
| {WB} | {1:500-2000} |
| {IHC-P} | {1:100-500} |
| {IHC-F} | {1:100-500} |
| {IF} | {1:100-500} |
| {Flow-Cyt} | {2ug/test} |
Antigen retrieval: citrate buffer ( 0.01M, pH 6.0 ), Boiling bathing for 15min; Block endogenous peroxidase by 3% Hydrogen peroxide for 30min; Blocking buffer (normal goat serum,C-0005) at 37℃ for 20 min;
Incubation: Anti-VEGFR Polyclonal Antibody, Unconjugated(bs-3467R) 1:200, overnight at 4°C, followed by conjugation to the secondary antibody(SP-0023) and DAB(C-0010) staining

Primary Antibody (green line): Rabbit Anti-phospho-VEGF receptor 2 (Tyr1059) antibody (bs-3467R)
Dilution: 2μg /10^6 cells;
Isotype Control Antibody (orange line): Rabbit IgG .
Secondary Antibody : Goat anti-rabbit IgG-AF647
Dilution: 1μg /test.
Protocol
The cells were fixed with 4% PFA (10min at room temperature)and then permeabilized with 90% ice-cold methanol for 20 min at-20℃. The cells were then incubated in 5%BSA to block non-specific protein-protein interactions for 30 min at room temperature .Cells stained with Primary Antibody for 30 min at room temperature. The secondary antibody used for 40 min at room temperature. Acquisition of 20,000 events was performed.

HUVEC (Hu)Lysate at 30 ug
Primary: Anti-phospho-VEGF receptor 2 (Tyr1059) (bs-3467R) at 1/300 dilution
Secondary: IRDye800CW Goat Anti-Rabbit IgG at 1/20000 dilution
Predicted band size: 147 kD
Observed band size: 147 kD
风险提示:丁香通仅作为第三方平台,为商家信息发布提供平台空间。用户咨询产品时请注意保护个人信息及财产安全,合理判断,谨慎选购商品,商家和用户对交易行为负责。对于医疗器械类产品,请先查证核实企业经营资质和医疗器械产品注册证情况。
文献和实验[IF={{ 5.19 }}] {Zhu, Huaisen. et al. Ginsenoside Rg1 regulates thiram-induced chondrocytes’ apoptosis and angiogenesis in broiler chickens. ENVIRON SCI POLLUT R. 2022 Dec;:1-15} {WB} {Chicken}
[IF={{ 2.886 }}] {Yang Q et al. Anlotinib Suppresses Colorectal Cancer Proliferation and Angiogenesis via Inhibition of AKT/ERK Signaling Cascade. Cancer Manag Res . 2020 Jun 24;12:4937-4948.} {WB} {Mouse}
v468. chapter 4 WNT 细胞通路 检测细胞GSK3活性与表达水平
. Immunoblot using antibodies to phospho-Tyr279/216 can assess alterations in activity independent ofthe N-terminal phosphorylation, although phosphorylation atthis site is most likely to be constitutive (14) . 3. Immunoblot using antibodies to known
技术资料暂无技术资料 索取技术资料





